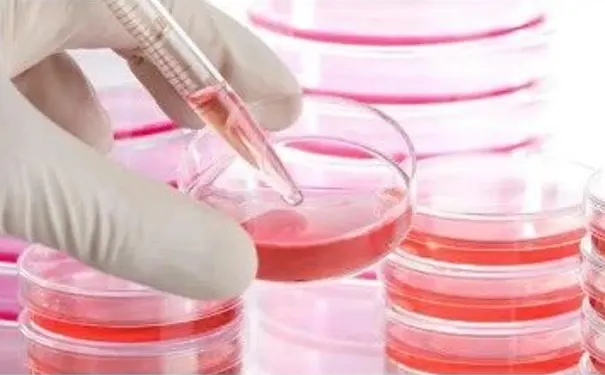
杭州博养压疮治疗中心

发布时间:2025-12-19 浏览量:0
上期为大家讲述了干细胞在糖尿病慢性创面中存在治疗作用。那么不同种类的干细胞是如何进行慢性创面治疗的呢?这期将继续为大家分享不同种类的干细胞促进创面治疗的具体机制。
创面愈合是一个复杂有序的生物学过程,包括了炎症反应,细胞增殖,结缔组织形成,创面收缩和创面重塑几个阶段。创面的愈合是炎症细胞,修复细胞,细胞因子,细胞外机制等多成分参与的相互协调的有序过程,任何一个成分出现差错,都可能导致创面不愈合。
目前,慢性创面不愈合的原因主要有几个方面:
1.炎症反应异常;
2.自由基的损伤作用
3.修复细胞功能异常:如表皮细胞,成纤维细胞,内皮细胞的功能障碍;
4.细胞因子的表达分泌异常;
5细胞外基质的改变。
而近年来,干细胞在再生医学领域受到广泛的关注与研究,在创面修复方面,干细胞也有着巨大的潜能,有望为临床上慢性难愈合创面提供一种新的治疗方案。

众所周知创面的修复是复杂的并且受很多因素的影响,如细胞因子,生长因子,趋化因子等。理论上来说,运用干细胞来治疗慢性创面,并不是只是靠干细胞的分裂增殖分化来覆盖创面,与此同时干细胞还可以作用于局部的微环境,释放各种因子来促进创面的愈合;另外,干细胞还可以在皮肤组织工程中作为种子细胞的来源,从而通过构建人工皮肤来封闭慢性难愈合创面。
胚胎干细胞对创面愈合的影响主要是通过其多能性分化成为其他前体细胞或者终末细胞实现的。胚胎干细胞诱导形成的血管内皮祖细胞可以分泌多种细胞因子,包括了大量的表皮生长因子(EGF),粒细胞巨噬细胞集落刺激因子(GM-CSF),IL-6.IL-8.IL-9.血小板源性生长因子(PDGF-AA)和血管内皮细胞生长因子(VEGF)等,而这些因子本身就可以促进创面的愈合,招募相关的炎性细胞,修复细胞的聚集以及促进血管生成。同时,由于局部创面胶原的合成量增加,愈合后创面的抗张强度更强。而局部胶原的沉积和肉芽组织的形成可以为细胞迁移提供支架,加速细胞迁移从而封闭创面。胚胎干细胞可被诱导向表皮细胞分化为角质形成细胞,再进一步诱导转化成为表皮干细胞,而表皮干细胞可进一步分化成为角质形成细胞。角质形成细胞则可以培养形成细胞膜片,这就为组织工程皮肤的构建提供了可能,从而通过构建的人工皮肤直接覆盖慢性难愈合的创面。
由于胚胎干细胞的应用引起了较为广泛的伦理学争论,以及胚胎干细胞可能存在的免疫斥的风险使干细应用受到了极大地限制,而诱导性多能干细胞技术的出现和发则为解决这一难题提供了新的方法与途径。通过基因技术可以将与某些干细胞相关的干基因导入成体细胞内再经过重编程使其变为多能干细胞,通过这样获得的干细胞由于从者身上取材相此有疫排斥反应同样也不存在伦理学方面的问题。
目前诱导性多能干细胞在细胞形态,生长特性表面标记物,基因表达模式以及分化模式等方面与胚胎干细胞极其相似,因此利用体细胞重新编程得到的导性诱导性多能干细胞经诱导化形成各种类型的细胞组织以及器官,再移植回体内治愈疾病,是一种比较理想的治疗疾病的模式。
表皮干细胞是皮肤出现损伤之后主要的修复细胞。其具有以下特征:多分化潜能,自我更新能力。其形态学上表现为体积小,核质比高,细胞器少,细胞呈球形,胞体亮,胞质相对原始等。很多因素都可以调控表皮干细胞的分化。首先是干细胞所处的环境,又称壁龛,由细胞成分,细胞外基质以及各种细胞因子构成,表皮干细胞在这一微环境中保持着自我更新和分化的平衡。此外,表皮干细胞还受到:
1.整合素-丝裂原激活蛋白激酶通路(MAPK);
2.原癌基因cyc;
3.Wnt信号通路
4.Notch信号转导通路;
5.细胞因子的调控。
表皮干细胞位于皮肤基层,生理情况下,表皮干细胞不断分化形成表皮的各层,完成皮肤的新陈代谢。在皮肤受损时,皮干细的分化明显加快。因此,通过研究以上调控表皮干细胞的分化的途径,可能促进表皮干细胞的分化进而用于治疗慢性难愈合创面。

脐带血干细胞由于其来源丰富,采集方便,对产妇及胎儿无任何痛苦和不良作用,受到了广泛的重视。由于脐带血干细胞中除了含有丰富的造血干细胞以外,还含有部分间充质干细胞日更原始有更强的化能力。因此也可能为慢性难愈合创面的治疗提供新的思路。但目前脐带血干细胞在再生医学中的应用多用于血液系统疾病,在创面修复方面的应用仍有待于进一步的研究。
许多疾病均可发生慢性创面,而干细胞在糖尿病慢性创面中存在治疗作用。上述为不同种类的干细胞的治疗作用,下期将继续为大家分享有关糖尿病足的治疗内容。